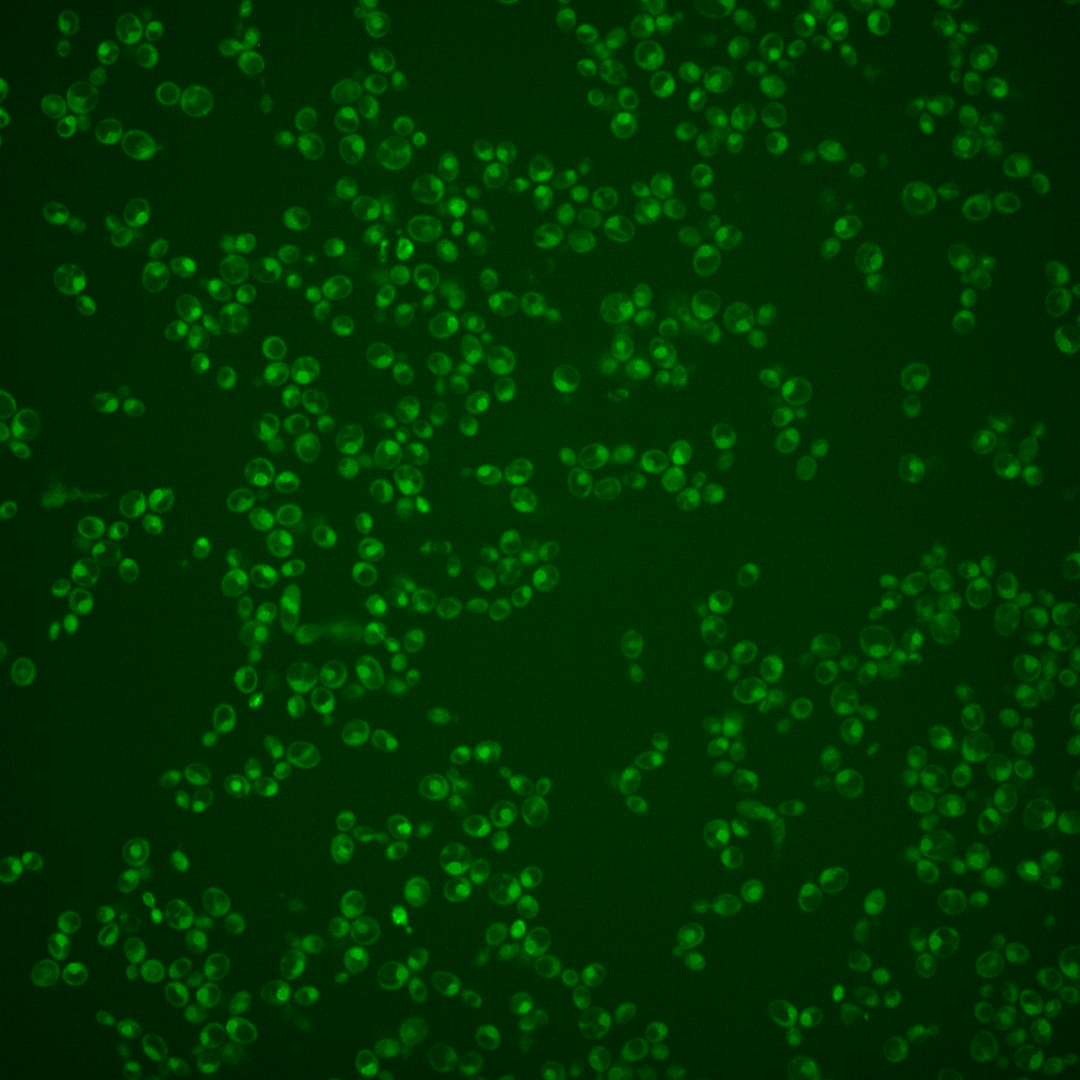
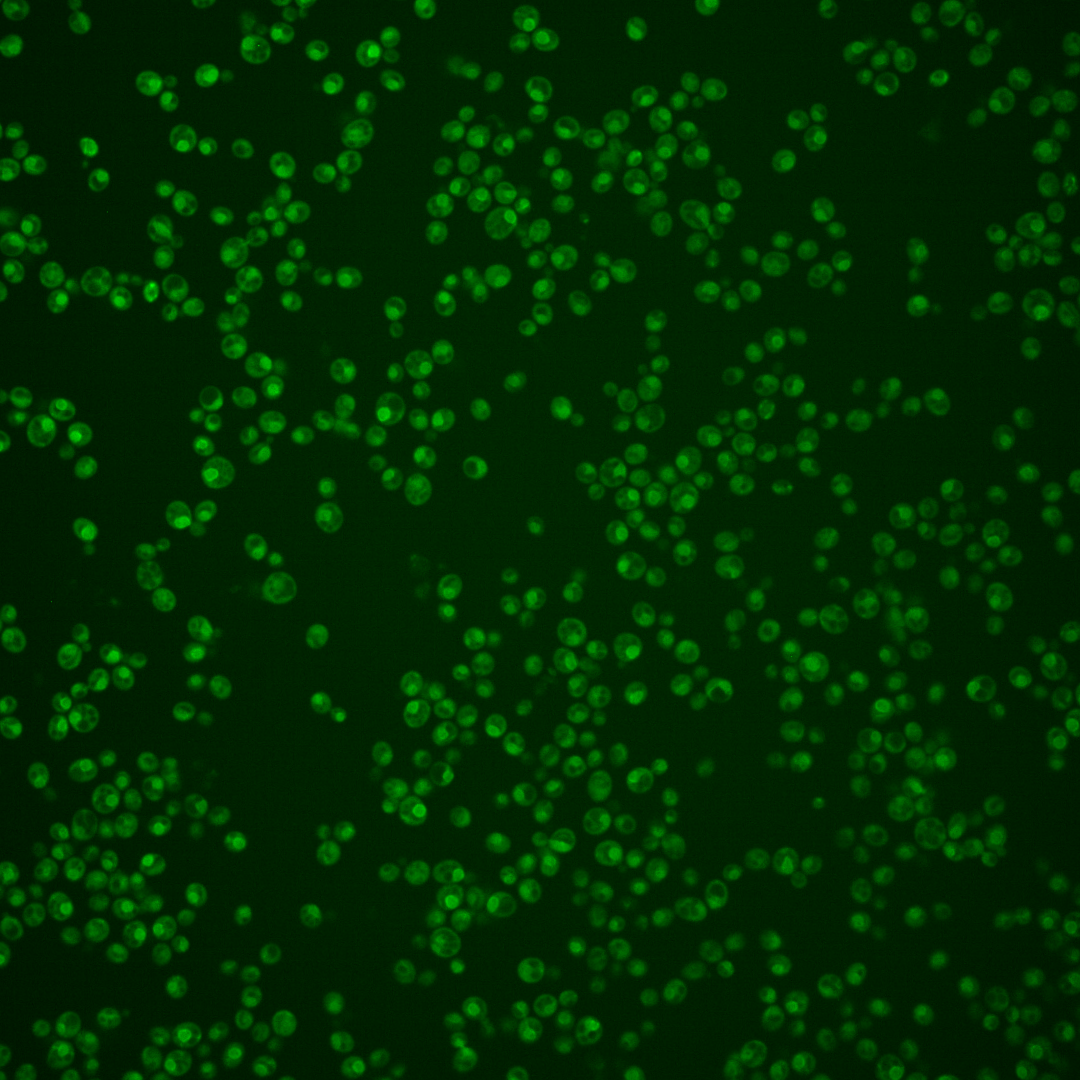
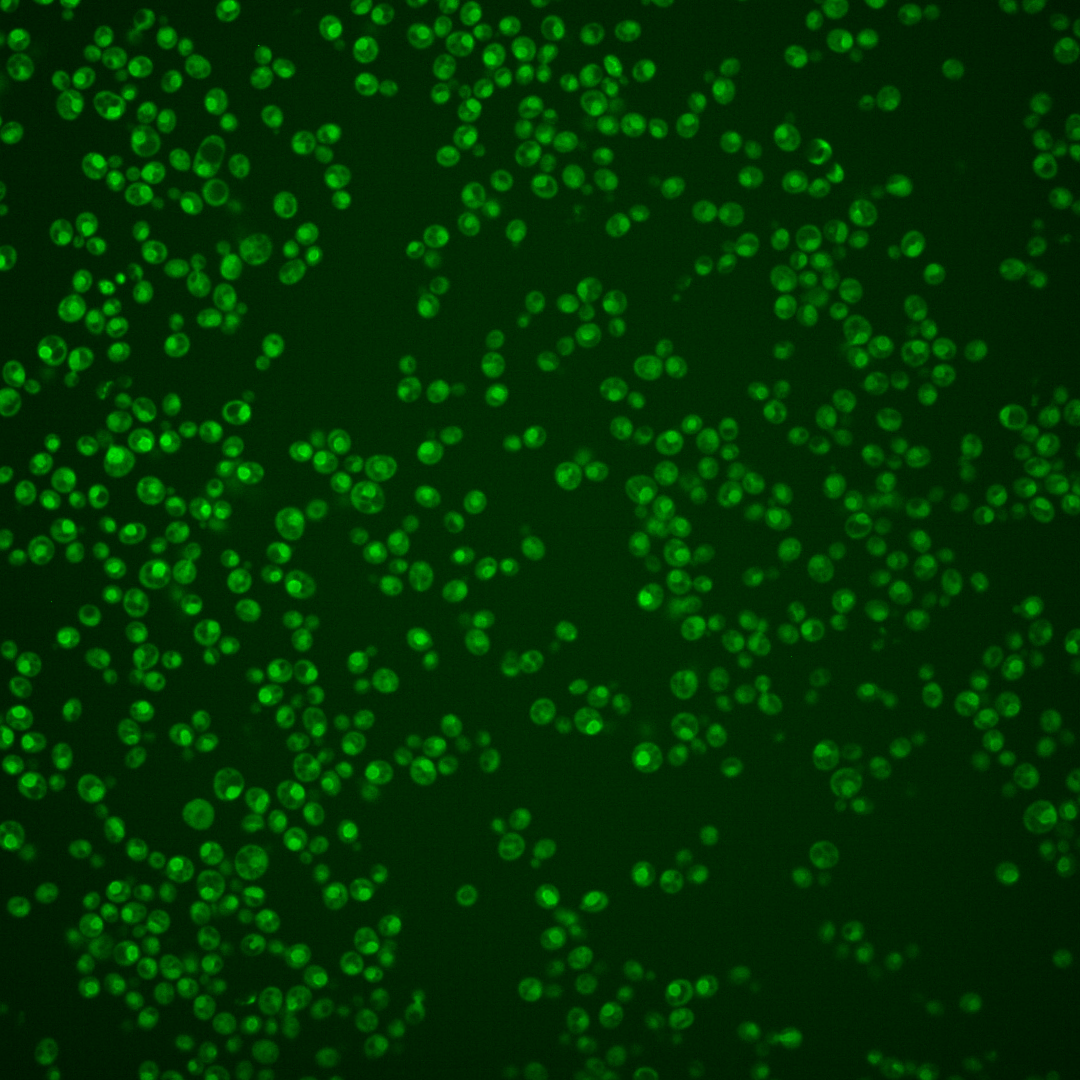
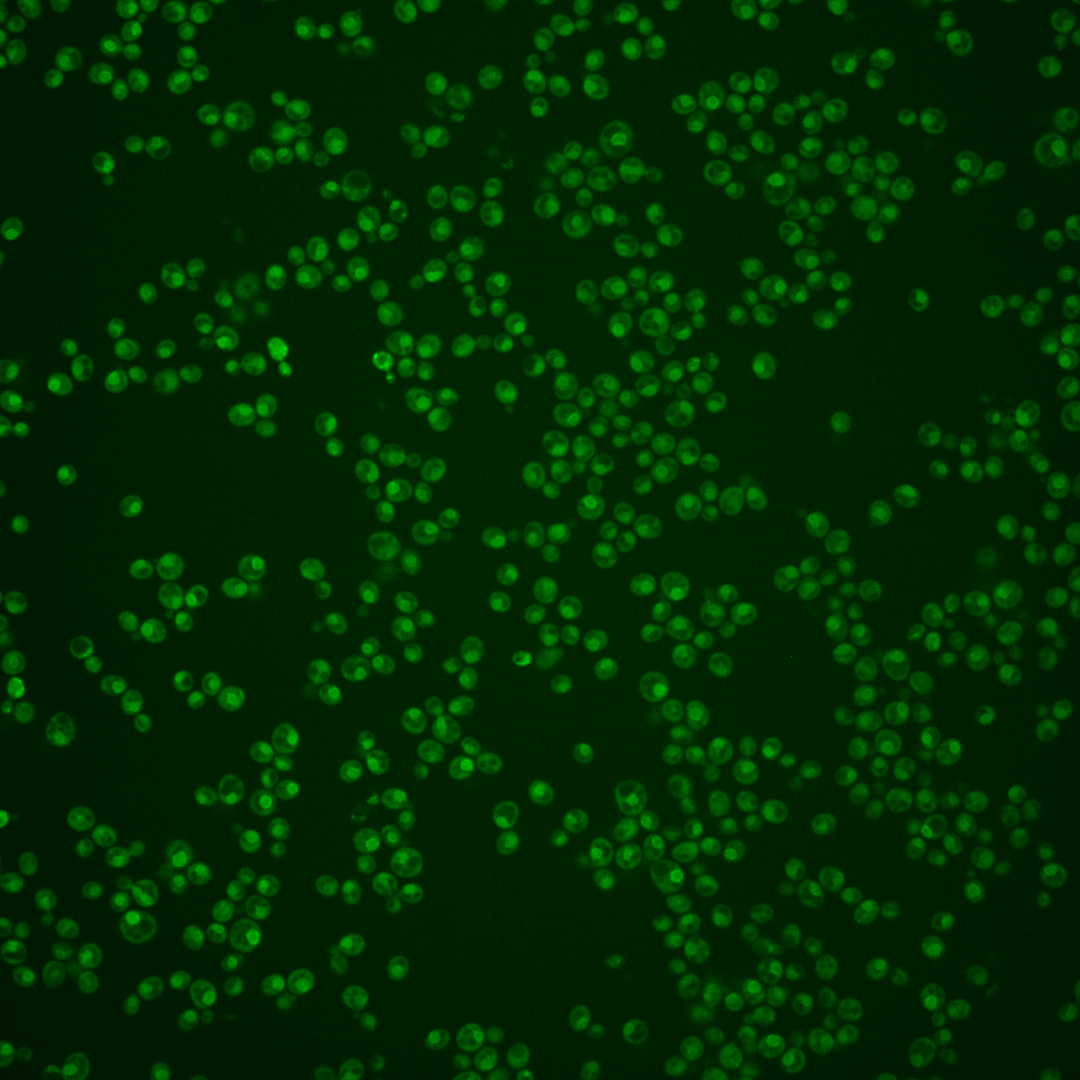
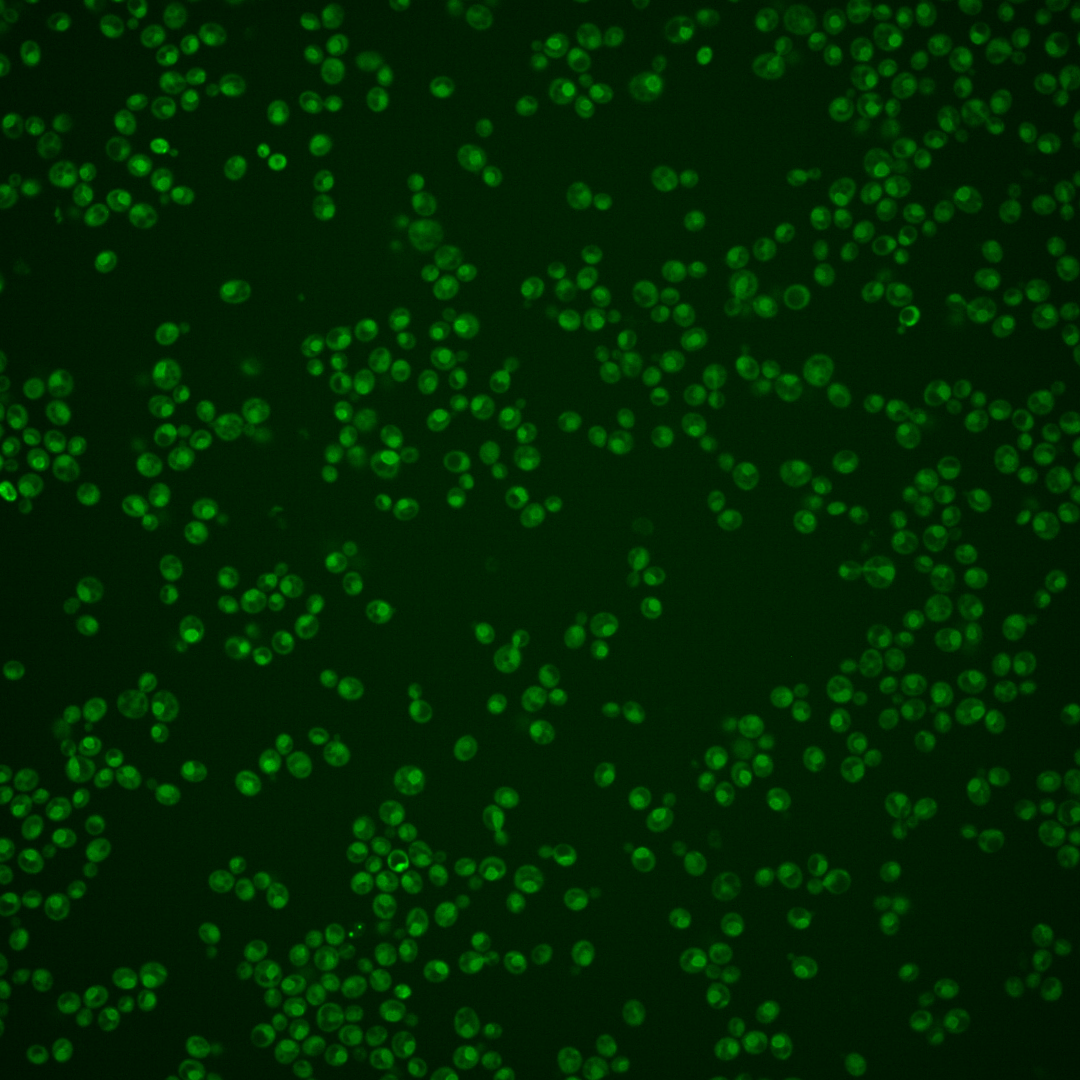

| Standard name | |
|---|---|
| Human Ortholog | |
| Description | Subunit of the inner nuclear membrane Asi ubiquitin ligase complex; the Asi complex targets both misfolded proteins of the inner nuclear membrane-associated degradation (INMAD) pathway and regulators of sterol biosynthesis for ubiquitin-mediated degradation; acts with Asi2p and Asi3p to ensure the fidelity of SPS-sensor signaling by targeting latent unprocessed forms of Stp1p and Stp2p, maintaining the repressed state of gene expression in the absence of inducing amino acids |
Micrographs




















































































Sub-cellular Localization
Yeast GFP Assignment
Protein Abundance
Localization Change
External localization resources
| ensLOC | DeepLoc | |||||||||||||||||||||||
|---|---|---|---|---|---|---|---|---|---|---|---|---|---|---|---|---|---|---|---|---|---|---|---|---|
| Localization | WT1 | WT2 | WT3 | RAP60 | RAP140 | RAP220 | RAP300 | RAP380 | RAP460 | RAP540 | RAP620 | RAP700 | HU80 | HU120 | HU160 | rpd3Δ_1 | rpd3Δ_2 | rpd3Δ_3 | WT1 | WT2 | WT3 | AF100 | AF140 | AF180 |
| Cortical Patches | 0 | 0 | 0 | 0 | 0 | 0 | 0 | – | 0 | 0 | 0 | 0 | 0 | 0 | 0 | 0 | – | 0 | 0 | 0 | 0 | 0 | 1 | 0 |
| Bud | 0 | 0 | 0 | 0 | 0 | 0 | 0 | – | 1 | 0 | 3 | 2 | 0 | 0 | 0 | 0 | – | 0 | 0 | 0 | 0 | 0 | 4 | 2 |
| Bud Neck | 0 | 0 | 0 | 0 | 0 | 0 | 0 | – | 0 | 1 | 0 | 0 | 0 | 0 | 0 | 0 | – | 0 | 0 | 0 | 0 | 0 | 0 | 0 |
| Bud Site | 0 | 0 | 0 | 0 | 0 | 0 | 0 | – | 1 | 2 | 3 | 2 | 0 | 0 | 1 | 0 | – | 0 | – | – | – | – | – | – |
| Cell Periphery | 0 | 0 | 0 | 0 | 0 | 0 | 0 | – | 0 | 0 | 0 | 0 | 0 | 0 | 0 | 0 | – | 1 | 0 | 0 | 0 | 0 | 0 | 0 |
| Cytoplasm | 9 | 11 | 3 | 15 | 9 | 27 | 39 | – | 7 | 23 | 27 | 45 | 12 | 43 | 63 | 4 | – | 1 | 3 | 2 | 2 | 8 | 27 | 33 |
| Endoplasmic Reticulum | 7 | 5 | 0 | 11 | 0 | 0 | 0 | – | 3 | 4 | 5 | 1 | 5 | 5 | 5 | 1 | – | 0 | 9 | 5 | 7 | 2 | 10 | 12 |
| Endosome | 1 | 1 | 1 | 0 | 5 | 4 | 11 | – | 0 | 3 | 0 | 4 | 0 | 2 | 4 | 1 | – | 1 | 3 | 0 | 0 | 0 | 7 | 8 |
| Golgi | 1 | 0 | 0 | 0 | 1 | 0 | 0 | – | 0 | 0 | 0 | 0 | 0 | 1 | 1 | 0 | – | 0 | 1 | 1 | 0 | 0 | 2 | 0 |
| Mitochondria | 55 | 4 | 0 | 3 | 6 | 15 | 44 | – | 40 | 41 | 157 | 125 | 0 | 0 | 1 | 1 | – | 3 | 14 | 10 | 1 | 10 | 31 | 39 |
| Nucleus | 6 | 14 | 1 | 12 | 29 | 52 | 98 | – | 45 | 65 | 73 | 112 | 13 | 27 | 41 | 1 | – | 0 | 1 | 3 | 0 | 3 | 24 | 25 |
| Nuclear Periphery | 46 | 21 | 0 | 1 | 22 | 34 | 36 | – | 24 | 32 | 38 | 33 | 22 | 50 | 45 | 4 | – | 3 | 135 | 119 | 25 | 33 | 62 | 64 |
| Nucleolus | 0 | 0 | 0 | 0 | 1 | 0 | 0 | – | 0 | 1 | 0 | 0 | 0 | 1 | 0 | 0 | – | 0 | 0 | 0 | 0 | 1 | 0 | 1 |
| Peroxisomes | 0 | 0 | 0 | 0 | 0 | 0 | 1 | – | 0 | 0 | 0 | 0 | 0 | 0 | 0 | 0 | – | 0 | 0 | 0 | 0 | 0 | 0 | 0 |
| SpindlePole | 0 | 0 | 0 | 0 | 0 | 0 | 1 | – | 0 | 1 | 0 | 3 | 0 | 3 | 2 | 0 | – | 0 | 4 | 1 | 0 | 1 | 9 | 5 |
| Vac/Vac Membrane | 101 | 121 | 17 | 42 | 108 | 88 | 124 | – | 25 | 60 | 65 | 97 | 58 | 95 | 129 | 29 | – | 19 | 11 | 19 | 5 | 9 | 52 | 99 |
| Unique Cell Count | 160 | 147 | 22 | 73 | 156 | 178 | 302 | 114 | 180 | 257 | 333 | 93 | 192 | 245 | 36 | 21 | 189 | 166 | 46 | 76 | 241 | 301 | ||
| Labelled Cell Count | 226 | 177 | 22 | 84 | 181 | 220 | 354 | 146 | 233 | 371 | 424 | 110 | 227 | 292 | 41 | 28 | 189 | 166 | 46 | 76 | 241 | 301 | ||
Yeast GFP Assignment
Protein Abundance
| Screen | WT1 | WT2 | WT3 | RAP60 | RAP140 | RAP220 | RAP300 | RAP380 | RAP460 | RAP540 | RAP620 | RAP700 | HU80 | HU120 | HU160 | rpd3Δ_1 | rpd3Δ_2 | rpd3Δ_3 | AF100 | AF140 | AF180 |
|---|---|---|---|---|---|---|---|---|---|---|---|---|---|---|---|---|---|---|---|---|---|
| Mean Cell GFP Intensity (1e-4) | 4.2 | 5.6 | 5.3 | 5.8 | 6.2 | 5.4 | 5.5 | – | 4.1 | 4.5 | 4.1 | 4.4 | 6.2 | 6.0 | 5.9 | 6.8 | – | 6.7 | – | 5.5 | 5.8 |
| Std Deviation (1e-4) | 0.4 | 1.0 | 0.6 | 1.5 | 1.6 | 1.5 | 2.2 | – | 0.9 | 0.6 | 1.1 | 1.2 | 0.9 | 1.1 | 1.2 | 1.0 | – | 1.6 | – | 1.1 | 1.0 |
| Intensity Change (Log2) | – | – | – | 0.12 | 0.23 | 0.02 | 0.04 | – | -0.38 | -0.24 | -0.39 | -0.28 | 0.22 | 0.17 | 0.14 | 0.35 | – | 0.34 | – | 0.06 | 0.12 |
Localization Change
| Localization | RAP60 | RAP140 | RAP220 | RAP300 | RAP380 | RAP460 | RAP540 | RAP620 | RAP700 | HU80 | HU120 | HU160 | rpd3Δ_1 | rpd3Δ_2 | rpd3Δ_3 |
|---|---|---|---|---|---|---|---|---|---|---|---|---|---|---|---|
| Cortical Patches | 0 | 0 | 0 | 0 | – | 0 | 0 | 0 | 0 | 0 | 0 | 0 | 0 | – | 0 |
| Bud | 0 | 0 | 0 | 0 | – | 0 | 0 | 0 | 0 | 0 | 0 | 0 | 0 | – | 0 |
| Bud Neck | 0 | 0 | 0 | 0 | – | 0 | 0 | 0 | 0 | 0 | 0 | 0 | 0 | – | 0 |
| Bud Site | 0 | 0 | 0 | 0 | – | 0 | 0 | 0 | 0 | 0 | 0 | 0 | 0 | – | 0 |
| Cell Periphery | 0 | 0 | 0 | 0 | – | 0 | 0 | 0 | 0 | 0 | 0 | 0 | 0 | – | 0 |
| Cytoplasm | 0 | 0 | 0 | 0 | – | 0 | 0 | 0 | 0 | 0 | 0 | 1.3 | 0 | – | 0 |
| Endoplasmic Reticulum | 0 | 0 | 0 | 0 | – | 0 | 0 | 0 | 0 | 0 | 0 | 0 | 0 | – | 0 |
| Endosome | 0 | 0 | 0 | 0 | – | 0 | 0 | 0 | 0 | 0 | 0 | 0 | 0 | – | 0 |
| Golgi | 0 | 0 | 0 | 0 | – | 0 | 0 | 0 | 0 | 0 | 0 | 0 | 0 | – | 0 |
| Mitochondria | 0 | 0 | 0 | 0 | – | 0 | 0 | 0 | 0 | 0 | 0 | 0 | 0 | – | 0 |
| Nucleus | 0 | 0 | 2.5 | 2.7 | – | 3.2 | 3.0 | 2.4 | 2.8 | 0 | 0 | 0 | 0 | – | 0 |
| Nuclear Periphery | 0 | 0 | 0 | 0 | – | 0 | 0 | 0 | 0 | 0 | 2.7 | 0 | 0 | – | 0 |
| Nucleolus | 0 | 0 | 0 | 0 | – | 0 | 0 | 0 | 0 | 0 | 0 | 0 | 0 | – | 0 |
| Peroxisomes | 0 | 0 | 0 | 0 | – | 0 | 0 | 0 | 0 | 0 | 0 | 0 | 0 | – | 0 |
| SpindlePole | 0 | 0 | 0 | 0 | – | 0 | 0 | 0 | 0 | 0 | 0 | 0 | 0 | – | 0 |
| Vacuole | -1.7 | -0.8 | -2.5 | -3.3 | – | -5.1 | -4.0 | -5.1 | -4.7 | -1.3 | -2.5 | -2.2 | 0.3 | – | 1.2 |
External localization resources
Images






























Protein Concentration and Protein Localization Data
| R1 | R2 | R3 | ||||||||||||||||
|---|---|---|---|---|---|---|---|---|---|---|---|---|---|---|---|---|---|---|
| G1 Pre-START | G1 Post-START | S/G2 | Metaphase | Anaphase | Telophase | G1 Pre-START | G1 Post-START | S/G2 | Metaphase | Anaphase | Telophase | G1 Pre-START | G1 Post-START | S/G2 | Metaphase | Anaphase | Telophase | |
| Concentration | -0.3996 | -0.2202 | -0.425 | -0.5693 | -0.2373 | -0.4193 | 0.4115 | 0.9174 | 0.7271 | 0.6962 | -0.0373 | 0.7653 | -0.2674 | -0.0653 | -0.4441 | -0.2823 | -0.3929 | -0.1992 |
| Actin | 0.0303 | 0.0002 | 0.0056 | 0.0009 | 0.0096 | 0.0192 | 0.0366 | 0.0001 | 0.0132 | 0.0012 | 0.002 | 0.007 | 0.0755 | 0.0002 | 0.0124 | 0.0397 | 0.0026 | 0.0218 |
| Bud | 0.0007 | 0 | 0.0003 | 0 | 0.0005 | 0.0001 | 0.0003 | 0 | 0.0007 | 0 | 0.0001 | 0 | 0.0002 | 0.0002 | 0.0002 | 0.0002 | 0.0007 | 0.0001 |
| Bud Neck | 0.0089 | 0 | 0.0002 | 0.0001 | 0.0004 | 0.0003 | 0.0052 | 0 | 0.0004 | 0.0001 | 0.0004 | 0.0004 | 0.0008 | 0.0038 | 0.0001 | 0.0003 | 0.0004 | 0.0005 |
| Bud Periphery | 0.001 | 0 | 0.0002 | 0.0001 | 0.0007 | 0.0001 | 0.0006 | 0 | 0.0011 | 0.0001 | 0.0003 | 0.0001 | 0.0003 | 0.0002 | 0.0002 | 0.0003 | 0.0011 | 0.0002 |
| Bud Site | 0.0109 | 0 | 0.0007 | 0.0001 | 0.0084 | 0.0002 | 0.0044 | 0 | 0.004 | 0.0001 | 0.0002 | 0.0002 | 0.0019 | 0.0072 | 0.0008 | 0.0013 | 0.0012 | 0.0006 |
| Cell Periphery | 0.0005 | 0 | 0.0001 | 0.0002 | 0.0002 | 0.0001 | 0.0002 | 0 | 0.0005 | 0.0001 | 0.0001 | 0 | 0.0001 | 0.0002 | 0 | 0.0001 | 0.0003 | 0.0001 |
| Cytoplasm | 0.0223 | 0.0158 | 0.0268 | 0.0411 | 0.0363 | 0.0184 | 0.0077 | 0.0073 | 0.0054 | 0.0101 | 0.0065 | 0.0055 | 0.0129 | 0.0101 | 0.0131 | 0.0134 | 0.022 | 0.0117 |
| Cytoplasmic Foci | 0.0247 | 0.0024 | 0.0079 | 0.0036 | 0.0218 | 0.0014 | 0.0054 | 0.0002 | 0.0064 | 0.0015 | 0.0018 | 0.0044 | 0.0367 | 0.0023 | 0.0081 | 0.0034 | 0.0123 | 0.0128 |
| Eisosomes | 0.0006 | 0 | 0.0002 | 0.0001 | 0.0002 | 0.0001 | 0.0003 | 0 | 0.0006 | 0.0002 | 0.0001 | 0 | 0.0006 | 0 | 0.0001 | 0.0002 | 0.0002 | 0.0002 |
| Endoplasmic Reticulum | 0.084 | 0.0698 | 0.0566 | 0.0643 | 0.007 | 0.0374 | 0.0257 | 0.0498 | 0.0313 | 0.0638 | 0.0098 | 0.016 | 0.0312 | 0.0548 | 0.0497 | 0.0406 | 0.0309 | 0.0194 |
| Endosome | 0.0363 | 0.0158 | 0.0171 | 0.017 | 0.0251 | 0.0063 | 0.0124 | 0.0028 | 0.0127 | 0.0094 | 0.014 | 0.003 | 0.0137 | 0.0035 | 0.007 | 0.0073 | 0.0528 | 0.0103 |
| Golgi | 0.0135 | 0.0002 | 0.0056 | 0.0024 | 0.0107 | 0.0006 | 0.0072 | 0 | 0.0051 | 0.0008 | 0.0062 | 0.0006 | 0.009 | 0.0002 | 0.0017 | 0.001 | 0.0178 | 0.0068 |
| Lipid Particles | 0.0259 | 0.0066 | 0.0197 | 0.0346 | 0.0242 | 0.0178 | 0.0189 | 0.0003 | 0.0125 | 0.006 | 0.034 | 0.0015 | 0.0396 | 0.0016 | 0.0028 | 0.0029 | 0.0541 | 0.0138 |
| Mitochondria | 0.0088 | 0.0009 | 0.0194 | 0.0237 | 0.0136 | 0.0022 | 0.0045 | 0.0008 | 0.0087 | 0.003 | 0.04 | 0.0011 | 0.0051 | 0.0009 | 0.0039 | 0.0024 | 0.0652 | 0.0046 |
| None | 0.0347 | 0.0082 | 0.0709 | 0.1521 | 0.0381 | 0.0262 | 0.0123 | 0.0547 | 0.0208 | 0.0427 | 0.0969 | 0.0411 | 0.0363 | 0.0319 | 0.0287 | 0.0364 | 0.0389 | 0.0144 |
| Nuclear Periphery | 0.6284 | 0.8141 | 0.6979 | 0.5883 | 0.6683 | 0.7759 | 0.7905 | 0.8118 | 0.814 | 0.8038 | 0.7118 | 0.8654 | 0.6416 | 0.7944 | 0.7923 | 0.795 | 0.5368 | 0.7898 |
| Nucleolus | 0.0021 | 0.0002 | 0.0008 | 0.0009 | 0.0011 | 0.0015 | 0.0008 | 0.0003 | 0.0005 | 0.0002 | 0.0017 | 0.0018 | 0.0003 | 0.0128 | 0.0002 | 0.0003 | 0.0013 | 0.0007 |
| Nucleus | 0.0197 | 0.0305 | 0.0212 | 0.0174 | 0.0164 | 0.0685 | 0.0347 | 0.0396 | 0.0156 | 0.0157 | 0.0358 | 0.0255 | 0.0232 | 0.0326 | 0.0384 | 0.0202 | 0.1129 | 0.0599 |
| Peroxisomes | 0.0087 | 0.0001 | 0.0133 | 0.0123 | 0.0962 | 0.0005 | 0.0076 | 0 | 0.0043 | 0.0003 | 0.0037 | 0.0002 | 0.0461 | 0.0003 | 0.0089 | 0.0017 | 0.0259 | 0.0092 |
| Punctate Nuclear | 0.014 | 0.0023 | 0.0031 | 0.0065 | 0.0051 | 0.0055 | 0.0043 | 0.001 | 0.0028 | 0.0008 | 0.0171 | 0.0109 | 0.0078 | 0.007 | 0.0022 | 0.0058 | 0.0027 | 0.0092 |
| Vacuole | 0.0048 | 0.0057 | 0.004 | 0.0059 | 0.0021 | 0.0021 | 0.0023 | 0.0022 | 0.0058 | 0.0026 | 0.0026 | 0.0011 | 0.0015 | 0.0037 | 0.0023 | 0.0019 | 0.0069 | 0.0014 |
| Vacuole Periphery | 0.0192 | 0.027 | 0.0282 | 0.0284 | 0.0142 | 0.0156 | 0.0181 | 0.0289 | 0.0334 | 0.0375 | 0.0149 | 0.0139 | 0.0156 | 0.0322 | 0.027 | 0.0257 | 0.0129 | 0.0126 |
Sequencing Data
| R1 | R2 | |||||||||
|---|---|---|---|---|---|---|---|---|---|---|
| G1 Post-START | S/G2 | Metaphase | Anaphase | Telophase | G1 Post-START | S/G2 | Metaphase | Anaphase | Telophase | |
| Gene Expression | 25.8932 | 16.8342 | 17.9568 | 23.5271 | 16.7858 | 23.5263 | 26.4623 | 23.335 | 25.7669 | 25.4986 |
| Translational Efficiency | 0.3457 | 0.4742 | 0.5146 | 0.4073 | 0.431 | 0.4724 | 0.4709 | 0.4847 | 0.4107 | 0.3644 |
Hit Data
| Dataset | Hit |
|---|---|
| Protein Concentration | ✘ |
| Protein Localization | ✘ |
| Gene Expression | ✘ |
| Translational Efficiency | ✔ |
Endocytosis
| Temp | Actin Patch (Sac6-tdTomato) | Cortical Patch (Sla1-GFP) | Late Endosome (Snf7-GFP) | Vacuole (Vph1-GFP) |
|---|---|---|---|---|
| 37℃ | ||||
| RT |
Cell Cycle Omics
CYCLoPs (Asi1-GFP)
| Gene / Allele | Actin Patch (Sac6-tdTomato) | Cortical Patch (Sla1-GFP) | Late Endosome (Snf7-GFP) | Vacuole (Sac6-tdTomato) |
|---|
| Gene | Images |
|---|
| Gene | Images |
|---|
Images are not yet available
Images are not yet available